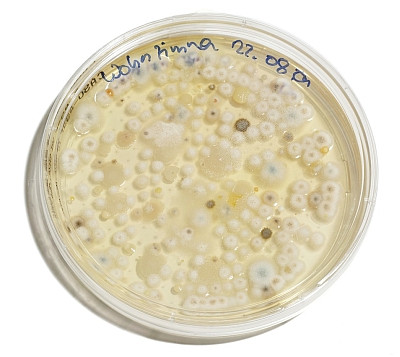
Labormäßige Schimmelanzucht aus Sporen (Befall Wohnzimmer)

Schimmel im Wohnraum
👁 Seitenaufrufe: 89
Schimmel im Wohnraum ist unschön und kann krank machen. Die folgenden Beiträge zeigen, wie er entsteht, welche baulichen Mängel vorliegen, welche Anzeichen es gibt und wie der Schimmel beseitigt wird.


#Schimmel! Igitt!
#Was Schimmelpilze mit Wärmebrücken zu tun haben
#Ratgeber zum Thema: Schimmelursachen erkennen und beseitigen
#e-book von Dipl. Ing. Frank Nowotka
Inhalt: Was sind Schimmelpilze? | Wachstumsvoraussetzungen | Gesundheitliche Beeinträchtigungen | Anzeichen für Schimmelbefall | Bauliche Mängel und ihre Beseitigung | Abbildungen typischer Schimmelschäden | Praxisfälle: Schimmelbefall und Beseitigung | Schimmel nach baulichen und gestalterischen Veränderungen | Was kann ich gegen Schimmelbefall tun? | Schimmel selbst entfernen | Weiterführende Links zum Thema Schimmel | Begriffe zum Thema Schimmelpilz | ca. 198 Seiten, 78 Fotos, Wärmebilder, Skizzen und Tabellen, mit Links zu zahlreichen weiterführenden Seiten bei energytools.de | eine PDF-Datei, optimiert fürs Handy, ohne Werbung, zum Preis von 5,35 €, incl. USt. 7%, sofort kaufen und auf dem Handy lesen jetzt kaufen
#Ein Schimmel kommt selten allein
Den Begriff Schimmel gibt es bereits seit einigen hundert Jahren in der deutschen Sprache. Bezeichnet wurde damit eine meist dunkle Fleckenbildung auf unterschiedlichen Materialien. Schon von Anfang an war klar, dass die Vorgänge, die zur Fleckenbildung führten, offenbar mit Feuchtigkeit zu tun haben. Allerdings dauerte es noch eine ganze Weile, bis die technischen Voraussetzungen es zuließen, die „Stockflecken“ genauer zu untersuchen. Unter dem Mikroskop zeigte sich dann eine wundersame Landschaft aus filigranen Strukturen, wogenden Fäden und farbigen Kratern, die von einer Anmutung sind, als wären wir auf einem Tauchgang im Korallengürtel einer karibischen Insel. Die großen Ähnlichkeiten mit dem Erscheinungsbild von Pilzmyzel schuf einen neuen Begriff: aus Schimmel wurde Schimmelpilz.
Inzwischen wissen wir, dass auch diese Einteilung nicht ganz korrekt ist, denn auf den so genannten „Stockflecken“ finden wir neben den Schimmelpilzen eine bunte Mischung aus Bakterien, Milben und Amöben. Den mengenmäßig größten Anteil haben aber meist die Schimmelpilze.
#Schimmelsporen sind immer und überall vorhanden.

Schimmel im Wohnraum vermehrt sich über Sporen. Etwa 100.000 Schimmelpilzarten soll es geben. Sporen von rund 300 Arten sind in jedem Wohnraum in geringen Mengen nachweisbar. Ihnen kann man sich also trotz umfangreicher Hygienemaßnahmen nicht entziehen. Und mit diesen Sporen fängt alles an. Irgendwo landet eine solche Spore, trifft auf eine günstige Nahrungsgrundlage und ein wenig Feuchtigkeit. Das Auskeimen kann beginnen. Trotzdem: Der Mensch hat sich an das natürliche Vorkommen von Schimmelpilzen und deren Sporen gut angepasst. Wenn es aber zu einem massenhaften Auftreten bestimmter Arten kommt, können nach heutigem Wissensstand Allergien, Bronchialerkrankungen und andere gesundheitliche Probleme entstehen.
ausführlich in
#Nimmt das Schimmelproblem zu?
Seit Mitte der 70er Jahre nahmen Schadensfälle mit Schimmel im Wohnraum in den alten Bundesländern und kurz nach 1989 in den östlichen Bundesländern zu. Mit dem in dieser Zeit zu beobachtenden starken Anstieg der Energiepreise und den Bemühungen, die Energiebilanz der Wohnungen durch bauliche Maßnahmen zu verbessern, beschleunigte sich diese Entwicklung. Auch die deutliche Zunahme des Wasserverbrauches für Körperpflege und Spaßbaden bis zum Höhepunkt 1990 hinterließ Spuren. Obwohl der Wasserverbrauch bis 2024 wieder zurückgegangen ist, sehen wir eine weiterhin hohe Nachfrage nach Lösungen für Schimmelprobleme. Die stärkere Hinwendung zu Materialien mit organischer Grundlage, z.B. bei Farben, Beschichtungen, Verkleidungen etc.. scheint die Zunahme zu beflügeln. Wie Untersuchungen zeigen, sollen ca. 25 % aller Wohnungen davon betroffen sein. Der Leidensdruck der Mieter und Eigentümer hat ein erhebliches Ausmaß, was sich bei meinen Untersuchungen im Rahmen der Energieberatung bestätigt hat.
#Wie kann man der unangenehmen Sache begegnen?

Ohne Sachverstand lässt sich eine nachhaltige Schimmelbeseitigung nicht bewerkstelligen. Doch leider setzen auch Bau-Fachleute oftmals eine ratlose Miene auf, wenn sie zu den Ursachen befragt werden. Meist sind die Antworten wenig differenziert, und gelegentlich komplett falsch. So meinen viele, allzu üppige Energiesparmaßnahmen seien Schuld am Schimmel im Wohnraum. Wärmedämmung lässt das Haus schließlich „nicht mehr atmen“. Andere machen moderne Fenster und Türen verantwortlich, die einfach "zu dicht" seien. Vermieter sind mit dem Hinweis schnell dabei, dass von den Mietern zu wenig geheizt und/oder gelüftet würde.
Nun, es ist wie immer. An fast allem ist was dran, aber keine der aufgeführten Ursachen trifft vollständig ins Schwarze. Dazu ist die ganze Sache zu komplex und viele „Ratschläge“ beißen sich mit den Erfahrungen der vor Ort gehenden Handwerker und Berater. Tatsache ist, Schimmel gab es schon immer. Aber die Massenhaftigkeit des Auftretens heute ist tatsächlich ein neues Phänomen.
ausführlich in:
#Eskalierender Schimmelkrieg

Schimmel im Wohnraum an Wänden, Möbeln, Textilien ist nicht nur unangenehm, sondern auch gesundheitlich bedenklich. Mieter und Eigentümer probieren – häufig erfolglos – das eine oder andere Mittelchen. Zwischen den über die Ursachen streitenden Parteien kommt es nicht selten zu einem wenig hilfreichen, aber an Schuldzuweisungen reichen Nervenkrieg. Und im Schadensfall stehen die Betroffenen nicht immer als Gewinner da.
Auch Gutachten und die darauf beruhende Rechtsprechung zeigen einen widersprüchlichen Wissensstand. Anders sind mitunter völlig entgegengesetzte Entscheidungen nicht erklärbar. Dabei scheint der Hintergrund des Phänomens so kompliziert eigentlich nicht. Bezüglich der Streitenden drängt sich allerdings der Eindruck auf, dass es neben fehlendem Wissen vor allem die mangelnde Bereitschaft ist, gewohnte Verhaltensweisen zu überdenken und ggf. zu ändern. Als Haupthindernis dafür kann die geringe Kenntnis der Zusammenhänge angesehen werden.
#Wie gefährlich ist Hausschimmel?
Zur den gesundheitlichen Gefahren, die von Schimmelpilzen ausgehen, gibt es unterschiedliche und offenbar nicht immer gesicherte Standpunkte. Tatsache ist, dass einige Schimmelpilzarten bei ihrem Wachstum giftige Stoffwechselprodukte (Pilzgifte Aflatoxine, Mycotoxine) bilden. Unbestritten haben einige Arten auch allergieauslösende Wirkungen. Andere Arten besiedeln den Menschen direkt (Atemwege, Lunge, Innenohr, Außenohr, Nasennebenhöhlen). Auch toxische Reaktionen durch flüchtige Stoffwechsel-Gifte (VOC) werden beobachtet, so z.B. in Form von Kopfschmerzen, Reizungen der Schleimhaut, Abgespanntheit, Konzentrationsstörungen. Betroffen sind vor allem kranke oder vorgeschädigte Menschen.
ausführlich in: Gesundheitliche Beeinträchtigungen durch Schimmel
#Einfluss der Bausubstanz und verschiedener gestalterischer Veränderungen
Für die Bausubstanz selbst ist das Zerstörungspotenzial differenziert zu bewerten. Während eine Schimmelpilzkolonie auf der Tapete wenig zerstörerische Kraft auf die wesentliche Bausubstanz entwickelt, sieht es bei einem starken Befall auf porösen Putzen, Trockenwänden aus Gips oder auf Holzwerkstoffplatten schon anders aus.
Allerdings sind bauliche Mängel nicht nur die Folge, sondern sehr häufig selbst die Ursache für massives Schimmelwachstum. Die Mängelbeseitigung ist kein geringes Problem. Es bedarf Sachverstand und Kenntnis der Zusammenhänge, um die richtigen Schlüsse zu ziehen.
ausführlich in
- Bauliche Mängel und ihre Beseitigung
- Abbildungen typischer Schimmelpilzschäden
- Praxis: Hohe Heizkosten, Schimmelbefall
- Schimmelschutz-Rechner
Sehr häufig tritt ein Schimmelbefall nach baulichen oder gestalterischen Veränderungen in der Wohnung auf. So können scheinbar unverdächtige Dinge entscheidende Werte, wie die Höhe der relativen Luftfeuchtigkeit, so verändern, dass die Wachstumsbedingungen sich zum Positiven wandeln.
ausführlich in:
#Was ist zu tun?
Der wichtigste Ansatzpunkt für eine langfristige Vermeidung von Schimmelbefall ist die Beseitigung der das Wachstum förderlichen Lebensbedingungen. Das betrifft vor allem die Minderung zu hoher Luftfeuchtewerte in den Wohnungen. Obwohl das Gegenteil der Fall ist, trifft man jedoch häufig auf die Auffassung von zu trockener Heizungsluft im Winter. Das führt zu dem Glauben, dass die Luft eher befeuchtet werden müsse. Ich habe in hunderten Beratungsfällen nicht ein einziges Mal diese These durch Messwerte bestätigen können, aber in vielen Schimmelfällen Luftbefeuchter an den Heizkörpern vorgefunden.
Eine rasche Beseitigung von akutem Befall hilft, weitere starke Expositionen von Sporen und anderen Stoffwechselprodukten zu verhindern. Dafür existiert der eine oder andere Hausmittel-Tipp, der nicht immer zum Ziel führt. So ist die oft empfohlene Anwendung von Essig zur Beseitigung verschimmelter Oberflächen langfristig kontraproduktiv, weil der saure Essig den pH-Wert in einen Bereich bringt, der für das Wachstum verschiedener Schimmelpilzarten eher von Vorteil ist. Außerdem neutralisiert der Essig den im Putz befindlichen Kalk, so dass der Essig wirkungslos wird.
ausführlich in: